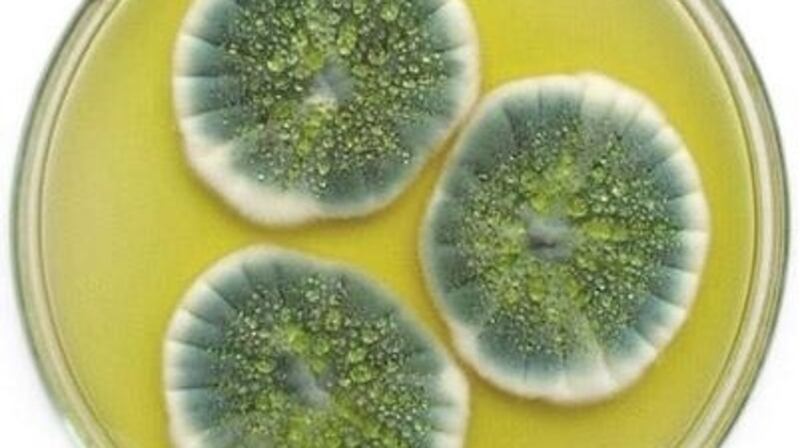
An endophyte growing on a culture dish

'Tell me the company you keep and I will tell you what you are." The musings of Sancho in Don Quixote might have been penned hundreds of years ago, but they remain relevant today when it comes to the microbes that call us home.
It is emerging that the bugs that live in our guts and on our skin can have an important impact on health. But what about the bugs that hang around plants?
Plants forge relationships with micro- organisms that can help them deal with stresses in their environments, and understanding the complexities of the shifting soil and plant microbiomes could help us to improve crop yields.

The micro-organisms that live inside plants without causing apparent disease are collectively known as endophytes. Dr Brian Murphy, a researcher at Trinity College Dublin and University College Dublin, is digging in this emerging field. "You could have as many as 20, 30 or even more types of endophytic fungi in a plant, even more bacteria and perhaps single-celled organisms called protozoans as well," he says. "They can all co-exist in the same plant."
Our understanding of the organisms that are communing with plants has improved in recent years thanks to new molecular techniques, and we are learning that microbes can help plants to deal with stresses in their environment.
"People have demonstrated over the last few years that microbes can confer benefits for plants over and above what the plant themselves can do," says Murphy. "An endophyte can enhance the plant's response to that stress to help them survive it better. Endophytes tend to regulate plant processes that help the plant cope with the stress, and research is showing that plants can recruit the microbes they need from the environment depending on the conditions."
Dynamic ways
Murphy is not entirely surprised that plants seem to change their microbial company to suit the challenges they face.
“Plants can’t move around like animals do; they are rooted in one spot,” he says. “So plants have developed these intimate relationships with micro-organisms because they have to. Plants may sit there for years – maybe hundreds of years in the case of a tree – and if the environment changes, then the plant needs dynamic ways to manage that. The endophyte relationship gives a plant some flexibility to respond to the environment.”
Murphy's research has looked at how barley crops cope with nutrient and heat stress as the plants associate with different microbes. "Over the last four years we have been running a lot of lab-based experiments with barley cultivars and endophytes isolated from their wild relatives," he says.
So far their field trials suggest that having the endophytes around helps the barley grow better under duress: when barley plants faced multiple stresses such as heat, drought, low soil nutrients and pests, they were about six times more likely to survive if the fungi were on hand.
“We got good increases in yield just out of putting the endophytes on the crops,” says Murphy, who works with Prof Fiona Doohan and Prof Trevor Hodkinson on the project. “Yield is a big one that farmers are interested in, because you get more grain. But we are also interested in how endophytes relate to how plants resist disease and also the protein and carbohydrate qualities of the grain.”
The researchers have just sown endophyte-treated seeds in three field locations, including one in Denmark, for this year's trials, which are being funded by Science Foundation Ireland.
The relationships between plants and endophytes can be quite specific, and engineering these microbial societies around crops is challenging, says Murphy.
Spraying solutions containing the microbes is one way, but he and colleagues have developed a “seed-dressing” technique that gets the endophytes and plants cosy together from the outset.
Endophyte mobility
The next step in the research is to look at how endophytes move between plants and to watch how communities change over time.
“We want to see how the endophytes in the soil move in and out of the plants during the course of a season,” he says. “This will help us better understand how we might manage crops beyond germination.”
As well as engineering “friendships” between microbes and plants for better crops, it is important to understand how soil microbes sequester carbon dioxide from the atmosphere, according to Dr Brian Kelleher, a lecturer at Dublin City University’s school of chemical sciences. His research looks at the microbial content and its function in soil organic matter.
“Our work has been showing that as much as 50-80 per cent of soil organic matter is microbial in origin,” he says.
- For more on endophytes visit Endophyte Club at the Field Test exhibition in Science Gallery Dublin, which runs until early June. See dublin.sciencegallery.com
BREAKTHROUGH: SUPERHERO BACTERIA FOR CROPS
In 2013, Emer Hickey, Ciara Judge and Sophie Healy-Thow won the BT Young Scientist and Technology Exhibition with their project on how diazotroph bacteria can give barley and oats a boost.
“We initially game up with the idea for our project when I was gardening with my mom,” says Hickey. “We noticed some wart-like nodules on the roots of pea plants, which prompted a conversation with our science teacher. She told the three of us about this bacteria and nitrogen fixation. We were only about 14 at the time and had very little knowledge about microbiology, so for us this bacteria sounded like a superhero.”
Learning about food security in geography class prompted the Kinsale trio to test the effects of Rhizobium bacteria on the non-legume food crop plants barley and oats. Their experiments showed that particular bacteria increased dry mass yield in barley, and they saw faster germination rates in both barley and oats.
Their investigation won top prizes at the BT Young Scientist title and the European Union Contest for Young Scientists in 2013 and at the Google Science Fair in 2014.
Last year Hickey and Judge set up Germinaid Innovations and they plan to continue the research.
“We hope to conduct many more lab-based experiments before expanding into larger field trials,” says Hickey. But first the teenagers need to do the Leaving Certificate this June.
“We plan to go full-force back into the project once in university,” says Hickey.









